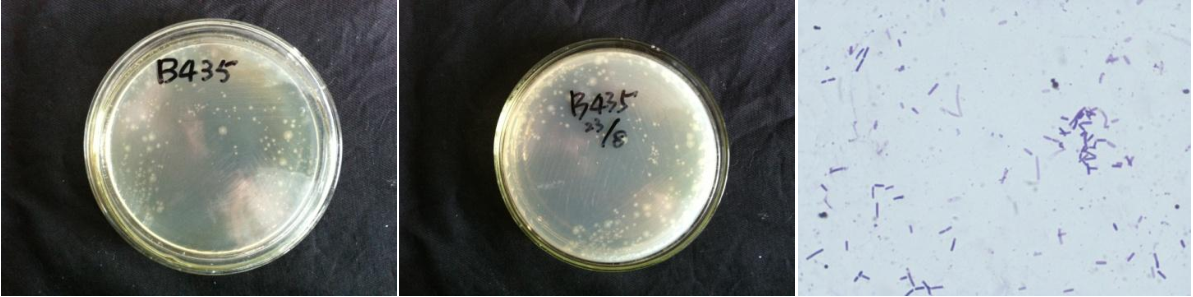

Loading...
| StrainNO | B435 |
| Classification | Brachybacterium |
| 16s rDNA sequence | AACGTATTCACCGCAGCGTTGCTGATCTGCGATTACTAGCGACTCCGACTTCATGGGGTCGAGTTGCAGACCCCAATCCGAACTGAGGC CGGCTTTTTGGGATTCGCTCCACCTCACAGTTTCGCAACCCATTGTACCGACCATTGTAGCATGCTTGAAGCCCAAGACATAAGGGGCA TGATGATTTGACGTCGTCCCCACCTTCCTCCGAGTTGACCCCGGCAGTCTCCTATGAGTCCCCACCATCACGTGCTGGCAACATAGAAC AAGGGTTGCGCTCGTTGCGGGACTTAACCCAACATCTCACGACACGAGCTGACGACAACCATGCACCACCTGTGCACCAGTCCAAAGAA AGCCACATCTCTGCAGCCGTCCAGTGCATGTCAAGCCTTGGTAAGGTTCTTCGCGTTGCATCGAATTAATCAGCATGCTCCGCCGCTTG TGCGGGCCCCCGTCAATTCCTTTGAGTTTTAGCCTTGCGGCCGTACTCCCCAGGCGGGGCACTTAATGCGTTAGCTACGGCGCGGAAAA CGTGGAATGTCCCCCACACCTAGTGCCCAACGTTTACGGCATGGACTACCAGGGTATCTAATCCTGTTCGCTACCCATGCTTTCGCTTC TCAGTGTCAGTAATGGCCCAGAGACCTGCCTTCGCCATCGGTGTTCTTCCTGATATCTGCGCATTTCACCGCTACACCAGGAGTTCCAG TCTCCCCTACCACACTCTAGCCTGCCCGTACCCACCGCACGCCCGAGGTTGAGCCTCGGGTTTTCACGGCAGACGCGACAAGCCACCTA CAAGCTCTTTACGCCCAATAATTCCGGACAACGCTTGCGCCCTACGTATTACCGCGGCTGCTGGCACGTAGTTAGCCGGCGCTTCTTCT GCAGGTACCGTCACTCTCGCTTCTTCCCTACTGAAAGGGGTTTACAACCCGAAGGCCGTCATCCCCCACGCGGCGTCGCTGCATCAGGC TTTCGCCCATTGTGCAATATTCCCCACTGCTGCCTCCCGTAGGAGTCTGGGCCGTGTCTCAGTCCCAGTGTGGCCGGTCGCCCTCTCAG GCCGGCTACCCGTCATCGTCTTGGTGAGCCATCACCTCACCAACAAACTGATAGGCCGCGAGTCCATCCCCCACCGATAAATCTTTCCA GCACCCACCATGCGATGAGTGCTCATATCCGGTATTAGCCACGATTTCCCGAGGTTATCCCGAAGTGGGGGGCAGGTTACT |
| Strain Morphology Photos | |
| Morphological Description | The morphology of Colony round;lime white;flat;edge neatly;light;sticky;translucent;The morphology of strain:Rod;no spores |